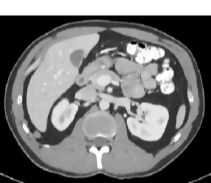

Cross Section at T12-L1 With CT
ID: 62435
Title:
Cross Section at T12-L1 With CT
Category:
Labeled-Cochard Imaging 1E Radiographs
Please describe! how you will use this image and then you will be able to add this image to your shopping basket.

Please Wait...
Please Wait...